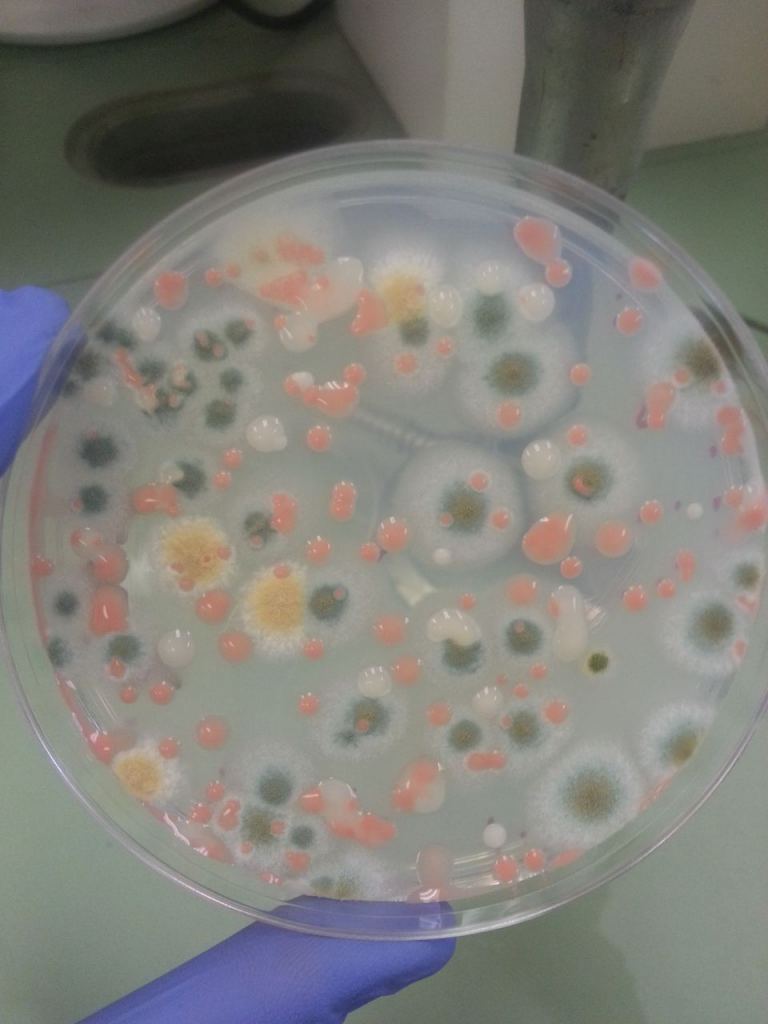

Humans aren't the only living things in place onboard the ISS. Bacteria, which has found a way to integrate itself into every biome on Earth, has also found a home in the aseptic microgravity of the space station high above it. Unfortunately, this poses a hazard to both the astronauts that live on the ISS and the station itself. But now, a team of researchers funded by ESA and the Instituto Italiano di Tecnologia (IIT) think they have a solution - make the surfaces on the ISS antimicrobial.
That is easier said than done - there are hundreds of different materials on the ISS, and each has its own mechanical and chemical properties. Scientists already know there are dozens of species of bacteria and fungi that live on the space station. Some are even dangerous to humans, such as *Staphylococcus aureus*, which can cause respiratory infections.
What's more, some of those bacteria can be harmful to the space station itself. Microbe colonies are known to form biofilms, which can eat through plastic, rubber, glass, and even metal if left untreated. In fact, the biofilm problem got so bad on Mir that there were concerns for the station's long-term viability before it was mothballed.
One obvious answer to this problem is to clean. But let's be honest - astronauts have much better things to do with their time. And, admittedly, they have a team of very brainy scientists who are being paid to develop a system for them never to have to clean again.
That system is supported by the "Optimization of Photo-catalytic Antibacterial coatings" or PATINA project and is funded by ESA's Open Space Innovation Forum. Other research paths in the project include superhydrophobic materials, though they have a different use case than the antimicrobial ones developed by IIT and ESA engineers.
Those antimicrobial coatings are based around titanium dioxide - a material that, when exposed to light, will break water vapor into "free oxygen radicals" that destroy any living thing touching its surface, including bacteria and fungi. Titanium dioxide also has advantages over the more traditional antimicrobial material - silver.
Silver has been used for its antimicrobial properties for centuries - it's why we have silverware. However, silver also has undesirable properties when a person is consistently exposed to it, such as eye and skin irritation. It can even change the color of a person's skin in high enough quantities. And it's much harder to avoid in the enclosed environment of the ISS rather than in the open air around most people's tables.
Titanium dioxide doesn't have any of those adverse side effects, at least so far known to science. The researchers developing this coating are actively trying to artificially age the coatings and damage them in as many ways as possible to ensure they aren't harmful. As Fabio Di Fonzo, one of the researchers from IIT, says, "Obviously, we don't want end products more toxic than the microbes themselves."
So far, they haven't found any hazardous side effects, and the team has successfully coated several different types of surfaces, including clean-room grade paper and aluminum foil, which is in abundant use on the ISS. They have also done so with layers as small as 50 to 100 nanometers in an attempt to maintain the mechanical properties of whatever surfaces they are coated on.
The total number of different types of surfaces exposed to bacteria in space will continue to grow as human space exploration evolves, and ESA is already taking the fight against harmful bacteria seriously. Two other ESA-supported projects are already researching bacterial growth on the ISS - MATISS, a French experiment, and a German experiment called Touching Surfaces. While it is inevitable that humans will share long-term space habitats with microbes of all kinds, it's best to do so so that it won't harm any humans or the craft they rely on.
Learn More:
ESA - Self-cleaning spacecraft surfaces to combat microbes
UT - Antibiotic Resistant Bacteria has been Found on the Space Station’s Toilet
UT - Bacteria Could Survive in Martian Soil
UT - Extreme Bacteria on the Space Station are Evolving to Handle the Harsh Conditions, not to Make Astronauts Sick
Lead Image:
Image of the ISS floating high above the Earth.
Credit - NASA
Universe Today